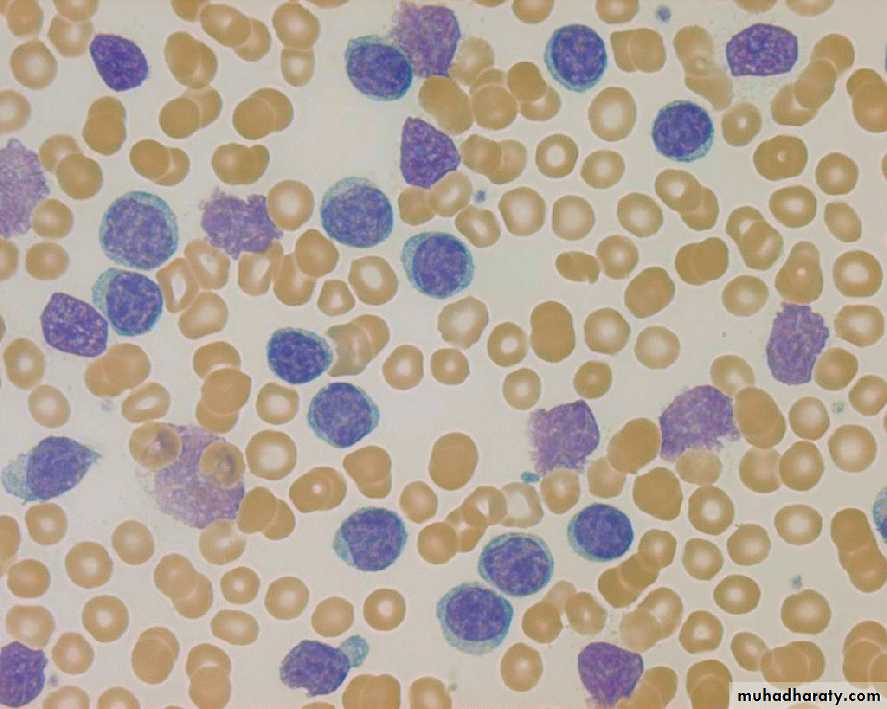

Fifth stage
MedicineLec-
د.خالد نافع
24/11/2015
CHRONIC LYMPHOCYTIC LEUKAEMIACLL
CLL is the most common leukemia in Westren countries, accounting for one-third of cases.
The disease is rare in Asians; 90% of patients are older than 50, median age at presentation is between 65 and 70 years
Men are affected more often than women by a ratio of 2:1.
PATHOOGY AND NATURAL HISTORY
PATHOLOGY;CLL RESULTS FROM SUPPRESION OF PROGRAMMED CELL DEATH(APOPTOSIS) OF MATURE B CELL.
SURFACE MEMBRANE ANTIGENS INCLUDE THE B CELL ANTIGENS CD 19, CD 20, CD23 . CD5 IS ALWAYS PRESENT ON CLL CELLS.
CD38 HAS BEEN ASSOCIATED WITH UNFAVORABLE PROGNOSIS
NATURAL HISTORY
1. Immunological abnrmalities;
a. Advanced disease is associated with hypogammaglobulinemia and decreased humoral respnses to antigens.
b. Avariety of in vitro lymphocyte function test are abnormal.
c. Coomb`s postive warm antibody hemolytic anemia occurs in 10% & immune thrombocytopenia in about 5%.
2. Clinical course
*Survival is closely correlated with the stage of disease at time of diagnosis.
*Because most of patients are elderly at time of diagnosis ; more than 30% die of diseases untrelated to leukemia.
A. Manifestation. In 70% of patients CLL is first recognized at routine physical exam.or by routine CBC.
Clinical manifestation develop as the leukemic cell acumalate on lymph nodes ,liver ,spleen & bone marrow .
Presenting problems may be anaemia, infections,painless lymphadenopathy, and systemic symptoms such as night sweats or weight loss. However, these more often occur later in the course of the disease.
Transformation in to a diffuse large B-cell lymphoma(Richter`s syndrome) or prolymphocytic leukemia occurs in less than 5% of patients.
B. progressive disease
*Death is usually due to infection , bleeding or other complicatin of the disease.1.HERPES ZOSTER is the cause of 10% infection in CLL.
2.Bacterial pathogens associated with
hypogammoglobuliemia include Streptococus pneumoniae
,Staphylococcus auerus and Hemophilus influenzae .
3.Pneumocystis jirovecii
Laboratory studies
1. Hemogram
a.Erythrcytes; anemia may be caused by
1.bone marrow infiltration.
2.hypersplenism
3.autoimmune hemolysis
b. Lymphocytes; the absolute count ranges from;
10x109/l - 200x109/l but may exceed 500x109/l.
*When blod smears are made , the cells are easily ruptured , producing typical “basket” or “smudge” cells.
c . Granulocyte; absolute counts are normal or increased until late in the disease.
d .Platelets; thrombocytopenia may prodused by bone marrow infiltration , hypersplenism, immune thrombocytopenia
lymphocytes
lymphocytes
‘smudge’ cells
‘smudge’ cells
CHRONIC LYMPHOCYTIC LEUKEMIA
*DIAGNOSIS1. Lymphocytes ( x109/L) > 5;
> 1 B-cell marker (CD 19, CD20 , CD 23) + CD5
2. Atypical cells (prolymphocyte) (%) < 55
3. Bone marrow lymphocytes ( %) >30
Binet Staging System
*Area of involvement considered for staging.
1. Head & neck , including the Waldeyer ring ( this counts as one area even if more than one group of nodes are enlarged )
2. Axillae ( involvement of both axillae count as one area)
3. Groins, including superficial femorals counts as one area.
Binet Staging System
Stage A. Hb > 100 g /L & platelets > 100 x109/L & up to two of the above lymph node involved.
Stage B. Hb > 100 g / L & platelets > 100 x109 / L & three or more areas of nodal or organ enlargement.
Stage C. All patients , irrespective of organomegaly in whom Hb < 100 g / L & or platelets < 100 x 109 / L.
Indications for Therapy in B cell- CLL
Anemia
Thrombocytopenia
Disease- related symptoms
Markedly enlarged or painful spleen
symptomatic lymphadenopathy
Blood lymphocyte count doubling time < 6 months
Prolymphocytic transformation
Richter`s transformation
RESPONSE CRITERIA
Complete remission(CR)Complete remission(CR)
PARTIAL REMISSION(PR)
PARTIAL REMISSION(PR)
TREATMENT
1-WATCH AND WAIT2-GLUCOCORTICOIDS3-ALKYLATING AGENTS
Chlorambcil (leukeran); alkylating agents.*Daily oral dose or Intermittently total oral dose every 2-4 weeks
CYCLOPHOSPHAMIDE
4-FLUDARABINE; Inhibit adenosine deaminase IV infusion 25- 30 mg/ m² daily for 5 days repeated 5-6 times every 3 - 4 weeks.
5- Anti-CD20 Rituximab.
Rituximab+Fludarabine+cyclophosphamide